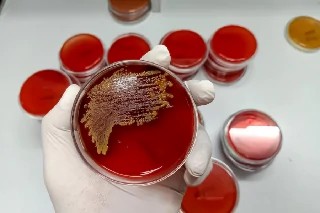
Curso gratuito de Básico em Bacteriologia Clínica

Noções de Primeiros Socorros
Conteúdo do Curso:
MATRÍCULA GRÁTIS